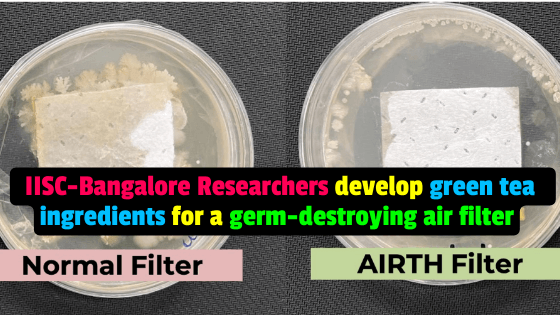

IISc-IIT researchers are developing air filters made from plant-based enzymes. The technology has been transferred to AiRTH, an IIT-Kanpur-incubated start-up. Filters can be installed on air conditioners, central ducts, and air purifiers.
Researchers at IISc and IIT create air filters out of plant-based enzymes. The air filter is installed on top of air conditioners (AC), central ducts, and air purifiers.
The technology has been transferred to AiRTH, an IIT-Kanpur-incubated start-up for marketing.
Scientists from the Indian Institute of Science (IISc) in Bengaluru and the Indian Institute of Technology (IIT) in Kanpur have created an antimicrobial air filter that can deactivate germs accumulated on it and purify the air in a room.
The air filter, which can be installed on top of air conditioners (AC), central ducts, and air purifiers, is made from plant-based enzymes found in green tea.
Plant-based enzymes with germ-killing properties, such as polyphenols and polycationic polymers, are coated on the filters.
Scientists at the IISc-IIT developed an air filter that uses plant-derived enzymes to destroy bacteria and viruses that could have been in the air. The filters can be mounted atop air conditioners and central ducts, which are also useful for controlling heat in the room.
Filter that can be attached to air conditioners, ducts, and air purifiers.
Scientists have developed an air filter that kills germs and keeps people safe from being harmed by air pollution.
Scientists at IISc, Bengaluru and IIT, Kanpur, have designed an antimoulded air filter that prevents germs from growing on it and purifies the air in a room.
Filters atop air conditioners, ducts, and air purifiers are made from plant-derived enzymes found in green tea. The air filters are made of plant-based enzymes found in green tea. They can be mounted on air conditioners, central ducts, and air purifiers.
The filter often sold in the market today is like a breeding ground for germs; if we use filters like those we have designed, germs can grow in the filters. We came across a gap in the market, which caused us to develop an air filter that can prevent air pollution and kill germs.
It uses plant-based enzyme compounds that are resistant to germs. They are highly effective against germs. It can keep you safe from air pollution and diseases caused by airborne pathogens. These antimicrobial air filters are compatible with air conditioners, ducts, and air purifiers.